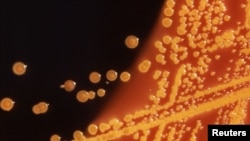
Колония бактерии E. Coli (кишечная палочка). Обычно она безвредна, но некоторые штаммы вызывают серьезные заболевания и обладают устойчивостью к различным антибиотикам

В прессе все чаще говорят о скором кошмарном будущем, где можно будет погибнуть от безобидного пореза: все лекарства окажутся бессильны против даже самой простой инфекции. Апокалиптические сценарии еще далеки от реальности, но проблема антибиотикорезистентности – устойчивости бактерий к лекарствам – с каждым годом становится все острее.
На прошедшей неделе в Давосе британский министр здравоохранения Мэтт Хэнкок призвал "предотвратить ужасное будущее", в котором люди окажутся беззащитны перед бактериями с множественной лекарственной устойчивостью (их иногда называют "супербактериями" или "супермикробами").
Представляя свой план борьбы, Хэнкок сравнил масштаб проблемы антибиотикорезистентности с войнами и изменением климата. Похожими формулировками оперирует Всемирная организация здравоохранения (ВОЗ) и специалисты по всему миру.
Насколько все плохо?
Ситуация пока не критическая, но очень серьезная. Бактерии научились противостоять даже самым сильным и редко применяемым лекарствам ("антибиотикам резерва", таким как колистин), при этом с 1980-х годов принципиально новых антибиотиков практически не появлялось. Исследования идут, но они слишком долгие и дорогие – а бактерии вырабатывают неуязвимость против антибиотиков куда быстрее. Дело осложняется и простотой путешествий: супербактерии получают возможность легко распространяться по всему миру.
Авторы британского исследования антибиотикорезистентности (2016 год) оценивали, что количество смертей от таких супербактерий в мире может вырасти примерно с 700 тысяч в год до 10 миллионов ежегодно к 2050 году – это больше, чем число жертв онкозаболеваний (на момент публикации). Потери ВВП при таком сценарии достигнут 100 триллионов долларов.
Пока не существует систем, позволяющих полноценно отслеживать мировую ситуацию с антибиотикорезистентностью в мировом масштабе. Проект ВОЗ под названием GLASS стартовал в 2015 году и по состоянию на конец 2018 года включал в себя лишь 71 страну. В последний отчет (опубликован в январе 2019 года) вошли данные об антибиотикорезистентности всего из 49 стран, при этом их качество пока не позволяет сравнивать между собой ситуацию в различных государствах и регионах.
В региональных отчетах также не много поводов для оптимизма. Страны Евросоюза за восемь лет (2007-2015) зафиксировали более чем двукратный рост числа погибших от инфекций, вызванных неуязвимыми для антибиотиков микробами, говорится в недавнем исследовании. По количеству потерянных лет здоровой жизни в пересчете на 100 тысяч населения (170) подобные инфекции практически сравнялись с суммарным эффектом ВИЧ, гриппа и туберкулеза (183). Более всего таким инфекциям в ЕС подвержены дети до года и люди старше 65 лет.
Хотя в еще одной свежей публикации крупный госпиталь Марселя показал, что за 15 лет (2001-2016) у них ситуация с резистентностью к антибиотикам не ухудшилась. К тому же, судя по мировой прессе, пока неуязвимые к абсолютно всем антибиотикам инфекции все же не носят массовый характер: громче всего обсуждали отчет двухлетней давности о 70-летней американке, погибшей от неуязвимой для всех антибиотиков бактерии (ее она скорее всего подхватила в Индии, где попала в больницу с переломом).
Какие именно организмы называют супербактериями?
Супербактерии (супермикробы) – это микроорганизмы, обладающие устойчивостью сразу к нескольким антибиотикам. Иногда – ко всем существующим.
В 2017 году ВОЗ опубликовала список из 12 бактерий, для борьбы с которыми срочно нужны новые антибиотики. Критически важны лекарства, способные справиться с устойчивыми к карбапенему энтеробактериями (например, кишечной палочкой E.Coli), синегнойной палочкой (Pseudomonas aeruginosa) и ацинетобактером (Acinetobacter baumannii). Чаще всего именно эти возбудители вызывают так называемые "внутрибольничные инфекции", с которыми врачам особенно сложно бороться из-за множественной устойчивости бактерий и ухудшенного состояния больных.
Также в список ВОЗ попали ванкомицин-резистентные энтерококки (Enterococcus faecium), невосприимчивый к метициллину и ванкомицину золотистый стафилококк (methicillin-resistant staphylococcus aureus, MRSA), цефалоспорин- и фторхинолон-резистентный гонококк, кларитромицин-резистентный хеликобактер и другие бактерии. Они вызывают серьезные болезни: заражение крови, менингит, пневмонию, инфекции мочевыводящих путей и гонорею.
Часто в материалах об антибиотиках фигурируют понятия “грамположительные бактерии” и “грамотрицательные бактерии”. Последние (например, кишечная палочка) обладают двумя клеточными мембранами: с ними сложнее бороться, и эффективных против них антибиотиков в мире меньше.
Как действуют антибиотики и появляется резистентность?
Антибиотики или "противомикробные препараты" – особые вещества, останавливающие рост клеток бактерий или уничтожающие их. Для этого существуют несколько механизмов: как правило антибиотики атакуют клеточную стенку, мешают синтезу белка или ДНК бактерий.
Резистентность к антибиотикам обнаружили вскоре после их появления. Первый в мире антибиотик – перевернувший медицину ХХ века пенициллин – Александр Флеминг открыл в 1928 году, но массово применять его начали лишь в 1942-м. Еще до этого, в 1940-м стало известно об устойчивой к пенициллину кишечной палочке.
Бактерии постоянно меняются, чтобы стать невосприимчивыми к действию антибиотиков: "выгодные" мутации передаются бактериями друг другу. Микробы приспосабливаются к антибиотикам даже в огромной концентрации крайне быстро. Посмотрите на видео, как всего за 11 дней кишечная палочка адаптируется к тысячекратной дозе (в центре) антибиотика:
Главными "инкубаторами" супербактерий оказываются больницы: там, где постоянно применяются мощные антибиотики, растут популяции невосприимчивых к ним микробов. Способствует развитию устойчивости бактерий и сельское хозяйство: там антибиотики широко применяют для профилактики болезней и ускорения роста животных.
Смертельна ли встреча с супербактерией?
Для здорового человека с нормальным иммунитетом – нет. Но чаще всего такие микробы встречаются в больницах, куда попадают люди, уже ослабленные той или иной болезнью. Для пациентов (например, находящихся на искусственной вентиляции легких) встреча с супербактериями может запросто стать фатальной.
Сейчас без антибиотиков невозможны сложные хирургические операции, трансплантации и борьба с раком посредством химиотерапии. Последняя обычно значительно подавляет иммунитет: для таких больных даже самая обычная инфекция может стать смертельной, не говоря уже о вызванной супермикробами.
При этом с инфекциями от мультирезистентных бактерий, пока на них действуют хоть какие-то антибиотики, можно жить, пусть даже это и будет сопряжено со страданиями.
Эмили Моррис рассказала, что супербактерию в ее мочевом пузыре обнаружили в подростковом возрасте, и с тех пор ей пришлось перепробовать множество антибиотиков, в том числе "препараты резерва" вроде карбапенема.
Во время беременности она была вынуждена принимать антибиотик, не проверявшийся на беременных, ее новорожденному ребенку пришлось сразу пройти курс терапии антибиотиками. "Это было очень страшно", – рассказывала 24-летняя Моррис журналу New Scientist в 2017 году.
32-летняя Кэтрин Уильямс уже более 10 лет постоянно принимает антибиотики из-за болезни мочевыводящих путей, вызванной супербактериями.
"Каждый раз, когда заканчивается курс приема антибиотиков, болезнь возвращается, – говорила она в интервью BBC. – Боль просто приковывает тебя к постели до следующего курса приема антибиотиков. То, что мне придется принимать антибиотики всю жизнь, меня очень пугает".
Почему так долго не появляются новые антибиотики?
За последние десятилетия арсенал медиков практически не пополнялся антибиотиками принципиально новых классов. Причин тому несколько.
Разработка таких лекарств – это сложное и затратное занятие, обходящееся в сотни миллионов или миллиарды долларов. Для фармакологических компаний оно не всегда интересно с коммерческой точки зрения: курсы антибиотиков обычно краткосрочны, в отличие от лекарств для хронических заболеваний (антиретровирусная терапия, например, людям с ВИЧ необходима всю жизнь). К тому же из-за быстрого возникновения резистентности растет риск обесценивания инвестиций в разработку новых препаратов.
Тем не менее, в последнее время вошли в обиход мощные антибиотики, полученные на базе старых открытий – в первую очередь, Линезолид (Зивокс). Да и представители существующих классов все время совершенствуются и нередко могут усиливать эффект при совместном использовании.
Что делать?
ВОЗ рекомендует использовать антибиотики только по назначению врача (а врачам – их разумно назначать) и всегда полностью проходить курс лечения, а не останавливать прием антибиотиков сразу после улучшения самочувствия.
Также рекомендуется не хранить, не использовать заново и не передавать другим оставшиеся дозы лекарства.
Важно не пытаться лечить вирусные заболевания антибиотиками, вакцинироваться, укреплять собственный иммунитет и тщательно соблюдать правила гигиены, рекомендует ВОЗ.
Также есть смысл по возможности избегать больниц в регионах, где санитарная ситуация далека от идеальной. В первую очередь – в Азии и Африке. По данным британского отчета, там к 2050 году будет больше всего погибших от инфекций супербактериями.
Если у вас или у близких есть подозрение на такую инфекцию, добейтесь консультации специалиста по инфекционным болезням. Недавнее исследование показало, что это может на 50% снизить смертность от инфекций, вызванных бактериями с множественной лекарственной устойчивостью.
Чего ждать в будущем?
Проблемой невосприимчивости к антибиотикам годами занимаются ученые и специалисты в области охраны общественного здоровья, и поводы для оптимизма есть.
ВОЗ в 2015 году одобрила глобальный план по борьбе с устойчивостью к противомикробным препаратам. Различные страны, в том числе США, Россия и совсем недавно Великобритания, принимают комплексы мер по борьбе с устойчивостью бактерий к антибиотикам. Они включают информирование пациентов и врачей о разумном использовании препаратов, ограничения на применение антибиотиков в сельском хозяйстве и содействие разработкам новых классов антибиотиков.
Несмотря на все сложности, такие разработки уже идут и появляются отдельные многообещающие результаты. Например, теиксобактин – принципиально новый антибиотик, открытый в 2015 году группой ученых из США, Германии и Великобритании.
В конце 2017 года его научились эффективно синтезировать, а в 2018-м действие синтетического теиксобактина успешно проверили на мышах. Но до появления лекарства для людей еще далеко: по оценкам ученых, 6-10 лет.
Оно может и вовсе не появиться: например, многообещающий платенсимицин, представленный в 2006 году, так и не добрался до полноценных клинических тестов из-за его неэффективности при введении стандартными методами. Однако исследования принципов работы платенсимицина позволяют надеяться на появление новых, более эффективных разработок.
В начале 2018 года ученые Рокфеллеровского университета в США представили еще один принципиально новый класс антибиотиков – малацидины, но до появления лекарств на их основе понадобится еще больше времени.
Рассматриваются и другие варианты терапии против супербактерий: целенаправленное усиление иммунитета, антимикробные пептиды, синтетические вещества, позаимствованные у вирусов, добавление особых элементов к уже существующим антибиотикам для повышения эффективности и другие способы. Однако все они пока находятся на разных стадиях готовности и для массового клинического использования не одобрены.

FACEBOOK КОММЕНТАРИИ: